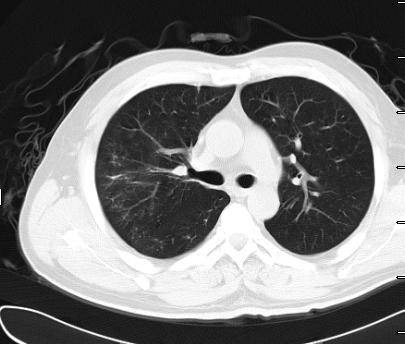

2016-07-05 07:50
作者 韩秀迪

责任编辑:曹彬 王一民
肺气囊:金黄色葡萄球菌肺炎典型影像学表现
作者:青岛市市立医院呼吸科 韩秀迪 刘学东
肺气囊是金黄色葡萄球菌肺炎的典型影像学表现,是支气管周围脓肿使终末细支气管和肺泡发生坏死,与支气管相通后坏死物质排空形成的薄壁空腔。当病原学明确并药敏证实为甲氧西林敏感金葡菌(MSSA)肺炎时,根据社区获得性肺炎(CAP)诊治6步法,应及时降阶梯治疗。
患者,男,42岁,电工,因“咳嗽、咳痰6天,发热3天,咯血2天”于2016-03-21收住青岛市市立医院呼吸科。
病 史
患者3月15日无明显诱因出现咳嗽、咳白粘痰,伴乏力、咽痛、周身酸痛,自服感冒药、阿奇霉素症状减轻;18日出现发热,最高39.4℃,伴畏寒,无寒战,稍感胸闷气短,当地医院予复方氨林巴比妥、利巴韦林、热毒宁治疗,体温降至正常。19日出现咯血,为鲜红色,量约30ml,上述症状较前加重,20日再次就诊于当地医院,行肺CT(图一)示“双肺炎”,遂转入我院急诊。既往高血压病史2年,无烟酒嗜好。

(图一)
检查结果(表一):

诊疗经过
入院后查体:体温38.2°C,心率106次/分,呼吸34次/分,血压115/67mmHg,听诊双肺中下野闻及爆裂音,偶可闻及散在哮鸣音。根据《中国成年人CAP诊断和治疗指南(2016版)》对重症CAP的诊断标准,该病人①RR≥30次/分;②PO2/FiO2≤250mmHg;③多肺叶浸润;④ BUN ≥7.14mmol/l(4项次要标准)符合重症CAP。患者为青壮年男性,有基础疾病,病情危重,入院后收住RICU。当时考虑流感季后易出现金黄色葡萄球菌感染,予替考拉宁+比阿培南抗感染并奥司他韦抗病毒治疗,甲强龙平喘抗炎抗渗出,无创机械通气改善氧合。入院当天及第二天2次送痰涂片(合格血痰)均找到G+球菌,住院第五天血及痰培养同时回报甲氧西林敏感金黄色葡萄球菌(MSSA)。患者经治疗后体温逐渐降至正常,咯血量逐渐减少,氧和指数逐渐升高,血相关炎性指标逐渐下降,抗感染治疗1周后复查肺CT(图二)提示双肺沿支气管血管束分布的肺气囊样改变。肺气囊为金黄色葡萄球菌肺炎的典型影像学表现,是支气管周围脓肿使终末细支气管和肺泡发生坏死,当与支气管相通后坏死物质排空形成的直径1-2.5cm、壁厚1-2mm、圆形或类圆形薄壁空腔,多发者似蜂窝肺。
根据第三版国际脓毒症和脓毒症休克诊断流程,该病人SOFA评分为4分(PO2/FiO2并呼吸支持3分+Cr1分)且乳酸>2 mmol/L,符合脓毒症的诊断。因此,该患者明确诊断为MSSA肺炎伴菌血症。

(图二)

转 归
患者经上述治疗后症状、体征均明显改善,好转出院。出院后3周门诊复查肺CT(图三)提示双肺病变基本吸收。
(图三)

经验教训
根据《中国成年人CAP诊断和治疗指南(2016版)》CAP诊治6步法,患者明确诊断为MSSA肺炎后应及时降阶梯治疗,但我们仍继续使用抗甲氧西林耐药金葡萄(MRSA)药物(替考拉宁)未及时调整治疗方案。这提示我们,今后应加强抗MRSA药物的临床应用管理,使抗感染治疗更规范。

以上文章为京港感染论坛独家编辑,转载需要获得许可,并标明来源,投稿热线:pidmic@126.com。


